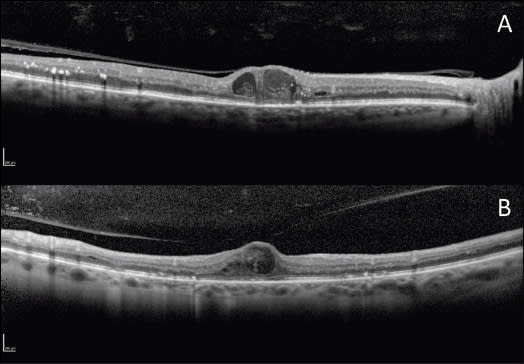

Choosing Candidates for Vitrectomy Among Refractory DME Cases
When is surgery the solution?
Payam Amini, MD • Giulio Barteselli, MD • William R. Freeman, MD
Various treatment modalities, including laser photocoagulation, intravitreal steroids, and intravitreal anti-VEGF drugs have been reported to be useful in the management of diabetic macular edema.1 Additionally, various reports have also shown favorable effects of pars plana vitrectomy for treating refractory DME with or without obvious abnormalities of the vitreoretinal interface.1
In this article we will discuss our rationale for choosing candidates for vitrectomy among refractory DME cases.
THE TREATMENT LANDSCAPE
The benefit and clinical utility of focal laser for the treatment of clinically significant DME was demonstrated in the Early Treatment Diabetic Retinopathy Study (ETDRS), which provided standard guidelines for focal laser photocoagulation. Direct treatment to leaking microaneurysms with grid treatment of diffuse DME or nonperfused thickened retina has been proved to stabilize clinically significant DME. Best corrected visual acuity improved in 16%, remained unchanged in 77%, and worsened in 7% of treated eyes after two years of follow-up.2
However, the conventional photocoagulation protocol may cause visible laser scars that can enlarge post operatively.3,4 Moreover, several other complications may occur, including decreased visual field,5 poorer night vision, reduced contrast sensitivity, and less commonly, subretinal fibrosis.6
| Payam Amini, MD, is a clinical fellow in retina at the University of California, San Diego (UCSD). Giulio Barteselli, MD, is a research fellow in retina at UCSD. William R. Freeman, MD, is professor and director of the Jacobs Retina Center at UCSD's Shiley Eye Center in La Jolla, CA. Dr. Freeman reports minimal financial interest in ODOS, Heidelberg, and Canon. He can be reached via e-mail at wrfreeman@ucsd.edu. |
To reduce retinal pigment epithelium damage and its complications, many investigators have tested the efficacy of subthreshold laser photocoagulation for the treatment of DME using micropulse infrared diode laser6-11 and the more recent navigated laser systems.12 These treatments have been suggested to maintain or improve BCVA and foveal thickness7-9,11,13, with minimal damage to the RPE.
Moreover, subthreshold laser photocoagulation was recently suggested to be as effective as conventional ETDRS threshold laser in reducing or eliminating DME.14,15 How ever, focal/grid threshold conventional laser remains the current standard of care for DME thus far. The limited improvement in BCVA after focal/grid laser and its incomplete effectiveness in reducing DME have prompted significant research into alternative therapies.
Steroids
In 2002 and 2003, papers highlighting the benefit of intravitreal injections of triamcinolone acetonide for DME were first published.16,17 Both the anti-inflammatory and anti-VEGF properties of intravitreal triamcinolone contribute to its effectiveness in treating DME refractory to laser photocoagulation.
Figure 1. A. An OCT linear scan shows a thickened posterior hyaloid, diffusely attached to the retinal surface, as well as cystoid macular edema and focal disruption of the IS/OS junction. B. An OCT linear scan shows vitreomacular traction, which may contribute to the development of DME.
However, the Diabetic Retinopathy Clinical Research Network (DRCR.net) reported that focal/grid laser is a better treatment than preservative-free intravitreal triamcinolone (1 mg or 4 mg) in eyes with DME involving the fovea.17,18 In a subsequent study by the DRCR.net, it was also shown that in pseudophakic eyes, intravitreal triamcinolone plus prompt laser seems more effective than laser alone.19
Controversy also exists as to whether 1 or 4 mg of intravitreal steroids given only four times over the three-year DRCR.net study is sufficient for an optimal response in DME. Given the transient beneficial response of low-dose steroids, some have argued that the conclusion reached by the DRCR.net is questionable. Higher doses of decanted triamcinolone (20 mg) can be used effectively in DME, achieving efficacy over many months without increased rate of ocular adverse events. Not surprisingly, steroid-related complications, such as glaucoma and cataract formation, must be considered,20 and patients must be monitored over longer periods of time, especially when given higher decanted doses. In the majority of cases, elevated intraocular pressures can be controlled adequately with ocular hypertensive medications.
More recently, injectable sustained-release steroid intravitreal implants have been studied for the treatment of DME, such as fluocinolone acetonide (Retisert) and dexamethasone (Ozurdex). After three years, Retisert implants led to a higher rate of resolution in DME than standard laser (58% vs 30%) and visual improvement of three or more lines (28% vs 15%).
However, 95% of phakic patients required cataract extraction, and 35% experienced medically uncontrolled increased IOP, requiring either removal of the implant or a glaucoma-filtering procedure.21 The effects of Ozurdex on DME are being investigated in a phase 3 trial. At this stage, the Food and Drug Administration has not approved these delivery systems for the treatment of DME.
Anti-VEGF
For a decade, animal studies have shown that VEGF levels in the vitreous are higher in animal models of diabetic retinopathy than in normal eyes.22 VEGF increases the vascular permeability of the retinal capillaries and stimulates vasculogenesis and angiogenesis, in response to retinal ischemia.
Many prospective randomized clinical trials have evaluated the efficacy of anti-VEGF compounds in the treatment of DME. The RESTORE study and the DRCR.net study have recently demonstrated that ranibizumab (with prompt or deferred laser, or as monotherapy without laser) is superior to standard laser alone23 and to triamcinolone 24 with respect to BCVA outcomes over three years.
The RISE and RIDE studies have also shown that monthly treatment with ranibizumab rapidly and sustainably improves vision, reduces the risk of further vision loss, and improves macular edema in patients with DME, when compared to sham injections.25 For many retina specialists, anti-VEGF injections have become the treatment of choice in patients with DME, especially if phakic and nonvitrectomized.
CASES CALLING FOR VITRECTOMY
Despite promising results with anti-VEGF use, refractory cases of DME are often seen by the retinal specialist. In these refractory cases, surgery may be considered. Induction of a posterior vitreous detachment, removal of taut posterior hyaloid and vitreomacular traction, removal of the internal limiting membrane, and a complete pars plana vitrectomy have been reported to resolve DME.1

Figure 2. An example of focal navigated laser treatment for DME. A. A color fundus pretreatment picture. B. Late-phase fluorescein angiogram. C-D. Early-phase fluorescein angiogram with detail of laser plan and no-treatment zone.
Many hypotheses exist regarding how vitrectomy may improve DME. There is clinical evidence that both tractional and nontractional factors at the vitreoretinal interface play an important role in the pathogenesis of DME.1
Removal of the vitreous gel can decrease the concentration of DME-promoting factors (such as advanced glycation end-products and VEGF) and can also improve oxygenation of the inner retina.26 In addition, release of any tractional forces at the vitreomacular interface may further improve the resolution of the DME and restore visual acuity.27
Over the last decade, various groups have observed a higher incidence of attached posterior hyaloids in eyes with DME. Presumably, contraction of the posterior hyaloid can induce traction and exacerbate macular edema.28,29
Due to persistent mechanical traction, diffuse macular edema may become refractory to the treatment modalities described above. Completed retrospective studies have shown the beneficial effects of vitrectomy and removal of taut premacular posterior hyaloids in diffuse DME.30,31
The DRCR.net has conducted a prospective study to evaluate the anatomic and functional outcomes of vitrectomy in eyes with DME in the presence of vitreomacular traction. Results at one year demonstrated significant anatomic improvement in mean central macular thickening; however, mean improvement in visual acuity from baseline was not significant.32

Figure 3. A. A baseline OCT linear scan shows a thickened posterior hyaloid, cystic macular edema, and bumped RPE in the fovea. B. A follow-up OCT linear scan three months after vitrectomy shows improvement of DME; however, the ELM is focally disrupted in the fovea, and the IS/OS junction is thickened.
So far, it is not clear whether peeling of the ILM is beneficial when performing vitrectomy for refractory DME.1 ILM peeling may prevent the formation of epiretinal membranes and may aid in removing the cortical vitreous that otherwise may be left behind, even after removal of the posterior hyaloid. Many investigators have already shown beneficial effects of ILM peeling in DME.33-35 However, no randomized prospective clinical trial has been performed yet to shed light on these theories.
Our Approach
At the Jacobs Retina Center at the University of California, San Diego, we use a stepwise approach when treating patients with DME and in choosing those that may benefit from vitrectomy.
Our initial treatment option in naïve DME patients includes anti-VEGF treatment, supplemented with focal/grid navigated laser. In particular, we are currently increasing the use of navigated laser photocoagulation. With this novel laser device, difficulties of slit-lamp laser delivery are minimized by the use of an eye-tracking system and in vivo imaging on a fundus camera platform, allowing for increased treatment accuracy and outcome.
Moreover, the physician controls the location of laser spots, utilizing an in vivo image of the patient's fundus. This allows for a precise and accurate pretreatment plan targeting microaneurysms and areas of edema without an ophthalmoscopical endpoint.12
Preliminary results detailing the effectiveness of navigated laser photocoagulation in the treatment of DME have been reported by our group.36 However, no randomized clinical trials have been performed with these devices so far.
In refractory patients, particularly if pseudophakic, we have used intravitreal steroids with good success. At our institution, we prefer to use intravitreal decanted triamcinolone (20 mg), acquiring long-term efficacy and limiting frequent repeat injections. We have a low threshold in initiating ocular hypertensive medications, and we have been able to control ocular hypertension in most patients without the need for more invasive procedures.
In individuals that are refractory to the above treatments, especially if phakic, we have been successful in improving DME and restoring vision with vitrectomy in those with an attached taut posterior hyaloid visualized on spectral-domain optical coherence tomography. We suggest peeling the posterior hyaloid toward the fovea, paying careful attention not to unroof the cysts of edema. If an ERM is present, it should be peeled with or without the use of diluted triamcinolone.
In cases of recurrent ERMs, indocyanine green-guided ILM peeling should be considered. To reduce ICG toxicity, isotonic dilution of the dye with balanced salt solution is mandatory; moreover, we suggest avoiding prolonged direct illumination of the dye, to prevent its photo-activation.
Furthermore, it is possible to predict visual improvement after vitrectomy in refractory DME patients. From a recent publication by our group, we learned that the strongest predictor of vision improvement was preoperative damage to the external limiting membrane, compared to the inner-segment/outer-segment junction.37 Thus, we suggest that high-resolution OCT be used as an integral part of DME management for a more thorough assessment of outer retinal structures, which are important in predicting outcome with vitrectomy.
CONCLUSION
In conclusion, vitrectomy for DME should be performed only in selected cases, especially those that appear refractory to laser, steroids, and anti-VEGF treatments. Many questions persist as to the mechanism of action of vitrectomy in refractory DME, the benefit of ILM peeling, and which patients can benefit most.
From the experience gained at our institution, when a decision is made to perform vitrectomy, we recommend a complete 25-gauge vitrectomy, careful removal of the posterior hyaloid and any significant ERM, and the use of an intraoperative decanted triamcinolone injection (20 mg) at the completion of the case. RP
REFERENCES
1. Bhagat N, Grigorian RA, Tutela A, Zarbin MA. Diabetic macular edema: pathogenesis and treatment. Surv Ophthalmol. 2009;54:1-32.
2. Photocoagulation for diabetic macular edema. Early Treatment Diabetic Retinopathy Study report number 1. Early Treatment Diabetic Retinopathy Study research group. Arch Ophthalmol. 1985;103:1796-1806.
3. Schatz H, Madeira D, McDonald HR, Johnson RN. Progressive enlargement of laser scars following grid laser photocoagulation for diffuse diabetic macular edema. Arch Ophthalmol. 1991;109:1549-1451.
4. Morgan CM, Schatz H. Atrophic creep of the retinal pigment epithelium after focal macular photocoagulation. Ophthalmology. 1989;96:96-103.
5. Striph GG, Hart WM, Jr., Olk RJ. Modified grid laser photocoagulation for diabetic macular edema. The effect on the central visual field. Ophthalmology. 1988;95:1673-1679.
6. Guyer DR, D'Amico DJ, Smith CW. Subretinal fibrosis after laser photocoagulation for diabetic macular edema. Am J Ophthalmol. 1992;113:652-656.
7. Laursen ML, Moeller F, Sander B, Sjoelie AK. Subthreshold micropulse diode laser treatment in diabetic macular oedema. Br J Ophthalmol. 2004;88:1173-1179.
8. Luttrull JK, Musch DC, Mainster MA. Subthreshold diode micropulse photocoagulation for the treatment of clinically significant diabetic macular oedema. Br J Ophthalmol. 2005;89:74-80.
9. Sivaprasad S, Sandhu R, Tandon A, Sayed-Ahmed K, McHugh DA. Subthreshold micropulse diode laser photocoagulation for clinically significant diabetic macular oedema: a three-year follow up. Clin Exp Ophthalmol. 2007;35:640-644.
10. Ohkoshi K, Yamaguchi T. Subthreshold micropulse diode laser photocoagulation for diabetic macular edema in Japanese patients. Am J Ophthalmol. 2010;149:133-139.
11. Nakamura Y, Mitamura Y, Ogata K, Arai M, Takatsuna Y, Yamamoto S. Functional and morphological changes of macula after subthreshold micropulse diode laser photocoagulation for diabetic macular oedema. Eye (Lond). 2010; 24:784-788.
12. Kozak I, Oster SF, Cortes MA, Dowell D, Hartmann K, Kim JS, et al. Clinical evaluation and treatment accuracy in diabetic macular edema using navigated laser photocoagulator NAVILAS. Ophthalmology. 2011;118:1119-1124.
13. Roider J, Brinkmann R, Wirbelauer C, Laqua H, Birngruber R. Subthreshold (retinal pigment epithelium) photocoagulation in macular diseases: a pilot
study. Br J Ophthalmol. 2000;84:40-47.
14. Kumar V, Ghosh B, Mehta DK, Goel N. Functional outcome of subthreshold versus threshold diode laser photocoagulation in diabetic macular oedema. Eye (Lond). 2010;24:1459-1465.
15. Vujosevic S, Bottega E, Casciano M, Pilotto E, Convento E, Midena E. Microperimetry and fundus autofluorescence in diabetic macular edema: subthreshold micropulse diode laser versus modified early treatment diabetic retinopathy study laser photocoagulation. Retina. 2010;30:908-916.
16. Martidis A, Duker JS, Greenberg PB, et al. Intravitreal triamcinolone for refractory diabetic macular edema. Ophthalmology. 2002;109:920-927.
17. Jonas JB, Kreissig I, Sofker A, Degenring RF. Intravitreal injection of triamcinolone for diffuse diabetic macular edema. Arch Ophthalmol. 2003;121:57-61.
18. Diabetic Retinopathy Clinical Research Network (DRCR.net); Beck RW, Edwards AR, Aiello LP, et al. Three-year follow-up of a randomized trial comparing focal/grid photocoagulation and intravitreal triamcinolone for diabetic macular edema. Arch Ophthalmol. 2009;127:245-251.
19. Diabetic Retinopathy Clinical Research Network; Elman MJ, Aiello LP, Beck RW, et al. Randomized trial evaluating ranibizumab plus prompt or deferred laser or triamcinolone plus prompt laser for diabetic macular edema. Oph thalmology. 2010;117:1064-1077.e35.
20. Diabetic Retinopathy Clinical Research Network. A randomized trial comparing intravitreal triamcinolone acetonide and focal/grid photocoagulation for diabetic macular edema. Ophthalmology. 2008;115(9):1447-1449.
21. Pearson PA, Comstock Tl, Ip M, et al. Fluocinolone acetonide intravitreal implant for diabetic macular edema: a 3-year multicenter, randomized, controlled clinical trial. Ophthalmology. 2011;118:1580-1587.
22. Nicholson BP, Schachat AP A review of clinical trials of anti-VEGF agents for diabetic retinopathy. Graefes Arch Clin Exp Ophthalmol. 2010;248:915-930.
23. Mitchell P, Bandello F, Schmidt-Erfurth U, et al. The RESTORE study: ranibizumab monotherapy or combined with laser versus laser monotherapy for diabetic macular edema. Ophthalmology. 2011;118:615-625.
24. Elman MJ, Bressler NM, Qin H, et al. Expanded 2-year follow-up of ranibiz-umab plus prompt or deferred laser or triamcinolone plus prompt laser for diabetic macular edema. Ophthalmology. 2011;118:609-614.
25. Nguyen QD, Brown DM, Marcus DM, et al. Ranibizumab for diabetic macular edema: results from 2 phase III randomized trials: RISE and RIDE. Ophthalmol ogy. 2012;119:789-801.
26. Stefansson E. Ocular oxygenation and the treatment of diabetic retinopathy. Surv Ophthalmol. 2006;51:364-380.
27. Lewis H, Abrams GW, Blumenkranz MS, Campo RV. Vitrectomy for diabetic macular traction and edema associated with posterior hyaloidal traction. Ophthalmology. 1992;99:753-759.
28. Kaiser PK, Riemann CD, Sears JE, Lewis H. Macular traction detachment and diabetic macular edema associated with posterior hyaloidal traction. Am J Ophthalmol. 2001;131:44-49.
29. Massin P, Haouchine B, Gaudric A. Macular traction detachment and diabetic edema associated with posterior hyaloidal traction. Am J Ophthalmol. 2001;132(4):599-600.
30. Pendergast SD. Vitrectomy for diabetic macular edema associated with a taut premacular posterior hyaloid. Curr Op¡n Ophthalmol. 1998;9:71-75.
31. Harbour JW, Smiddy WE, Flynn HW, Jr., Rubsamen PE. Vitrectomy for diabetic macular edema associated with a thickened and taut posterior hyaloid membrane. Am J Ophthalmol. 1996;121:405-413.
32. Diabetic Retinopathy Clinical Research Network Writing Committee; Haller JA, Qin H, Apte RS, et al. Vitrectomy outcomes in eyes with diabetic macular edema and vitreomacular traction. Ophthalmology. 2010;117:1087-1093.e3.
33. Gandorfer A, Messmer EM, Ulbig MW, Kampik A. Resolution of diabetic macular edema after surgical removal of the posterior hyaloid and the inner limiting membrane. Retina. 2000;20:126-133.
34. Rosenblatt BJ, Shah GK, Sharma S, Bakal J. Pars plana vitrectomy with internal limiting membranectomy for refractory diabetic macular edema without a taut posterior hyaloid. Graefes Arch Clin Exp Ophthalmol. 2005;243:20-25.
35. Kimura T, Kiryu J, Nishiwaki H, et al. Efficacy of surgical removal of the internal limiting membrane in diabetic cystoid macular edema. Retina. 2005;25:454-461.
36. Kozak I, Kim JS, Oster SF, Chhablani J, Freeman WR. Focal navigated laser photocoagulation in retinovascular disease: clinical results in initial case series. Retina. 2012;32:930-935.
37. Chhablani JK, Kim JS, Cheng L, Kozak I, Freeman W. External limiting membrane as a predictor of visual improvement in diabetic macular edema after pars plana vitrectomy. Graefes Arch Cln Exp Ophthalmol. 2012 Feb 23. [Epub ahead of print]








